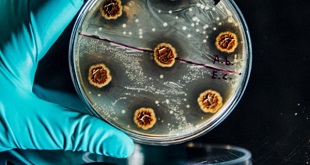

Millions in low- and middle-income countries could miss out on lifesaving drugs NEWS ANALYSIS | AGENCIES | Antibiotic production from big pharmaceutical companies has slowed significantly in the last five years, leaving children in low- and middle-income countries particularly exposed to hard-to-treat infections, according to new analysis. The …
Read More »Pharma pulls back as antimicrobial resistance threat grows
Currently, drug-resistant infections are responsible for over one million direct deaths per year, with AMR contributing indirectly to more than four million additional fatalities annually NEWS ANALYSIS | PATRICIA AKANKWATSA | The rising threat of antimicrobial resistance (AMR) continues to expose deep structural weaknesses in global pharmaceutical markets, with …
Read More »Fighting the Invisible Enemy: Ugandan medics take on antimicrobial resistance
In the second part of this series, we show how frontline medics are fighting for a future where routine infections do not become deadly again Kampala, Uganda | IAN KATUSIIME | Dr Lorna Atikoro works at Kiruddu National Referral Hospital and describes herself as a soldier in the fight against …
Read More »Uganda’s Silent Epidemic: the Growing Drug Resistance
In the first of a two-part series, experts warn that without urgent action, drug-resistant infections could cause millions of deaths per year NEWS FEATURE | IAN KATUSIIME | A narrow path glides through the slum of Katanga giving visitors a fleeting rhythm of the decades-long settlement that lies between …
Read More »‘Unless checked, antimicrobial resistance will cause more deaths annually than cancer’
Everyone has a role to play in combating AMR. Individuals and farmers can help by using antibiotics only when prescribed by a healthcare professional, completing the full course of treatment, and practicing good hygiene to prevent infections. COMMENT | Dr JacksonTwebaze Ndahayo | Antimicrobial resistance (AMR) poses a significant threat …
Read More »Protect the medicines that protect us
WHO charts new path for action against antimicrobial resistance (AMR) ANALYSIS | SHOBHA SHUKLA | Protect the medicines that protect us and ensure that all those who need them can access them, says Dr Tedros Adhanom Ghebreyesus, the Director General of The World Health Organization (WHO). He was speaking at a …
Read More »Global agencies urge urgent action to address antimicrobial resistance in Africa
Harare, Zimbabwe | Xinhua |– Global agencies have stressed the growing urgency for Africa to scale up efforts to combat antimicrobial resistance (AMR), amid its significant implications for global health and food security. Being the hardest hit by AMR, Africa needs political will across the continent to marshal resources towards …
Read More »Annual Muslim Run 2023 launched, to raise money for babies home in Luwero
Kampala, Uganda | THE INDEPENDENT | The 3rd edition of the Annual Muslim Run (AMR) set for 10th September 2023 starting at the Uganda Museum-Kampala has been launched by Bugiri Member of Parliament Asuman Basalira. Up to 7,000 participants are expected to compete in the event that started in 2019 with the aim of …
Read More »Half of the antibiotics prescribed in hospitals unnecessary: Experts
Kampala, Uganda | THE INDEPENDENT | Half of all antibiotics currently prescribed by doctors are not needed, experts attending World Health Organization-WHO meeting in which they were assessing strides made by countries on implementation of National Action Plans on Antimicrobial Resistance (AMR) have revealed. Speaking at the meeting on Tuesday, Dr. …
Read More »Fighting the next pandemic
Scientists around the world are already battling superbugs worse that COVID-19 | PROF. DAVID W GRAHAM AND PROF. PETER COLLIGNON | For many years, people believed antibiotic resistance in bacteria was primarily driven by imprudent use of antibiotics in clinical and veterinary settings. But growing evidence suggests that environmental factors …
Read More » The Independent Uganda: You get the Truth we Pay the Price
The Independent Uganda: You get the Truth we Pay the Price